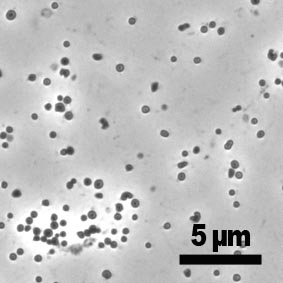

メタン生成古細菌
メタン生成古細菌は嫌気的環境下でメタンを生成する微生物群の総称で、そのすべては古細菌に分類されます。嫌気的環境下において有機物は複数種の微生物によって完全に分解されますが、メタン生成古細菌は嫌気的な有機物分解の最終段階を担っており、発酵性の細菌などが生成した水素、ギ酸、酢酸及びメチルアミン類といった限られた基質からメタンを生成することで増殖しています。
メタン生成古細菌は沼や河川などの堆積物、動物や昆虫の消化管、水田、海洋堆積物、嫌気性廃水処理リアクターなど嫌気的環境に普遍的に存在しています。また、その性状は好熱性から好冷性、好塩性など多様で、バラエティに富んだ微生物群です。
お問い合わせ
- 独立行政法人製品評価技術基盤機構 バイオテクノロジーセンター バイオ技術評価・開発課(かずさ)
-
TEL:0438-20-5764
住所:〒292-0818 千葉県木更津市かずさ鎌足2-5-8 地図
お問い合わせフォームへ